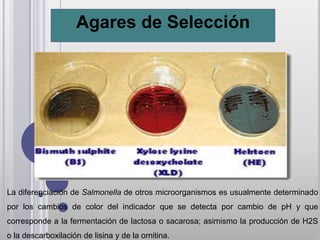
Agares de Selección




La diferenciación de Salmonella de otros microorganismos es usualmente determinado
por los cambios de color del indicador que se detecta por cambio de pH y que
corresponde a la fermentación de lactosa o sacarosa; asimismo la producción de H2S
o la descarboxilación de lisina y de la ornitina.

Este documento describe varias enterobacterias como E. coli, Shigella, Salmonella y Klebsiella. Detalla las características y pruebas bioquímicas de identificación de E. coli, incluyendo sus diferentes cepas patógenas como EPEC, ETEC, EAEC, ECAD y EHEC. También cubre brevemente a E. albertii, una especie recién descrita aislada en heces diarreicas.